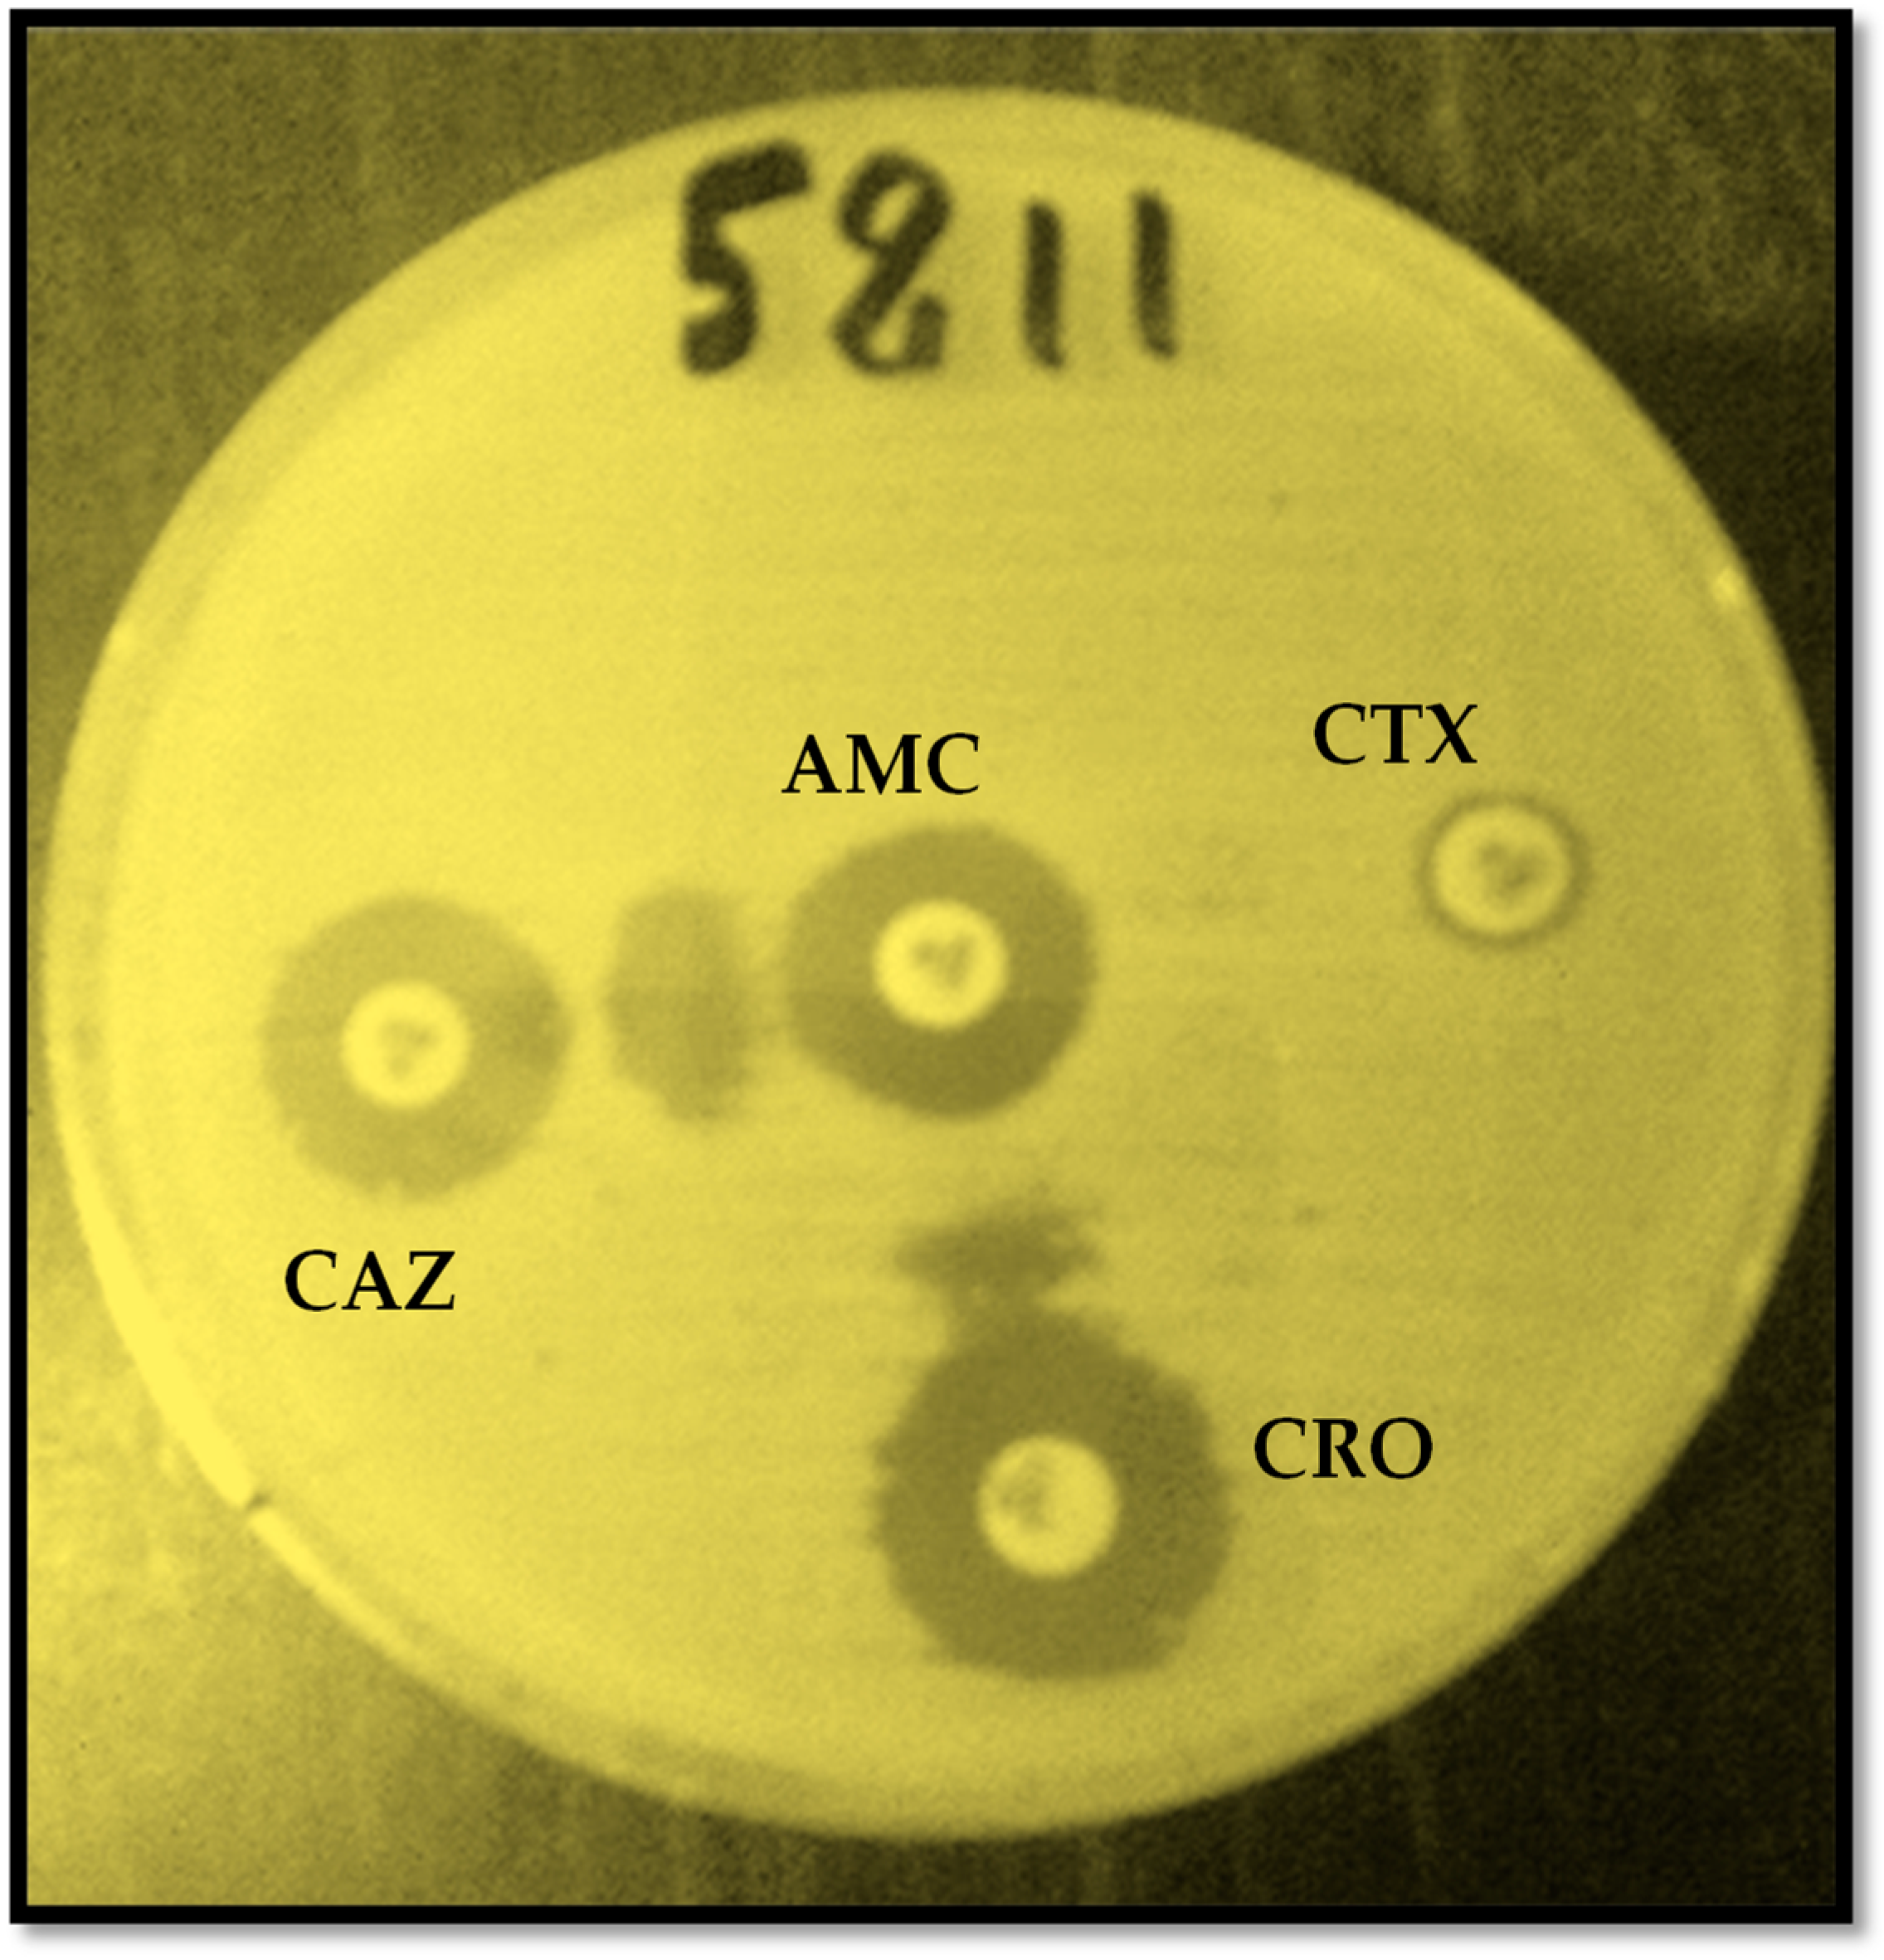
Uro 03 00026 g001

Abstract
Urinary tract infection (UTI) is a common patient infection and a major public health problem today. The rapid spread of antibiotic resistance genes in Enterobacterales, particularly in Extended-spectrum beta-lactamases producing Escherichia coli (ESBL-E. coli), is compromising treatment with the antibiotics that are normally used. The aim of this study was to evaluate the level of susceptibility of uropathogenic ESBL-producing E. coli to fosfomycin as an alternative treatment. A total of 3369 samples of urine were received and processed in the Bacteriology Laboratory of the Niamey General Reference Hospital (NGRH) throughout 2021. Synergy testing was performed for phenotypic detection of ESBLs, and fosfomycin sensibility of ESBLs-producing uropathogenic E. coli isolates were determined using the Viteck-2 system. Of the 280 enterobacteria identified in the urine samples, 104 Escherichia coli isolates were positive to the synergy test. The average age of the patients was 54 ± 17. The age range of 46–65 years was the most affected by these infections. The female patients predominated over the male ones, with a prevalence of 51.90%, a sex ratio of 1.08. The ESBL-producing E. coli isolates were 0.97% resistant to fosfomycin. Fosfomycin is highly effective against uropathogenic ESBL-producing E. coli isolates. It could be used as an alternative treatment for both uncomplicated and complicated urinary tract infections.
1. Introduction
Antimicrobial resistance has increased worldwide, thus leading to infections which are more difficult to treat, with higher mortality, morbidity, and costs. Beta-lactam resistance, particularly, is on the increase, and the production of antibiotic-inactivating enzymes in Gram-negative pathogens is one of the most common mechanisms of drug resistance [1]. The increasing ubiquity of Escherichia coli positive for the production of antibiotic-inactivating enzymes in both community and hospital settings has been shown by several studies [2]. ESBL (extended spectrum beta-lactamase)-producing E. coli are emerging enterobacteria responsible for urinary tract infections (UTI) in patients [3], and urinary tract infections provoked by these pathogens have become a major public health problem today [4,5]. An uncomplicated UTI is a bacterial infection of the lower urinary tract that is not associated with structural abnormalities of the urinary tract or comorbidities such as diabetes, immunosuppression, or pregnancy, whereas a complicated UTI is associated with structural abnormalities of the urinary tract or comorbidities such as the above [6]. Indeed, the appearance of these bacteria in urinary tract infections is a medical emergency [7,8] requiring long-term monitoring in order to implement appropriate probabilistic treatment [9]. A long time ago, the treatment for UTI was a challenge for physicians due to the emergence of multidrug-resistant uropathogens. In this regard, the treatment of urinary tract infections requires antibiotic therapy, which must be carried out conventionally on the basis of susceptibility test results to avoid the development of resistant mutants or partial cures [10].
At least, the treatment of bacterial infections suffers from the spread of multidrug-resistant (MDR) or extensively drug-resistant (XDR) pathogens and a lack of development of new antibiotics active against such MDR and XDR bacteria [11]. As a result, physicians have turned to older antibiotics. Fosfomycin is a bactericidal antibiotic produced by Streptomyces fradiaee and classified as a phosphonic acid. It has a broad activity against Gram-positive and Gram-negative pathogens and is particularly active against multi-resistant bacteria such as ESBL-producing Escherichia coli [12]. Fosfomycin is used in many countries around the world for a variety of indications, in both of its oral formulations (trometamol or calcium salt), in single doses of 3 g for the treatment of urinary tract infections [13,14]. Fosfomycin acts as a phosphoenolypyruvate analog, preventing the initial stage of cell wall synthesis via the inhibition of MurA (UDP-N-acetylglucosamine enolpyruvyl-transferase enzyme), which catalyzes the initial step of N-acetylmuramic acid and peptidoglycan biosynthesis, leading to bacterial cell death [15]. Fosfomycin is very well tolerated by the body, and adverse reactions vary from 1% to 5% of patients [16,17]. The ESBL-producing Enterobacteriaceae family has been detected worldwide, and the risk factors associated to it may be related to hospital care or antibiotic therapy. A recent study showed a high incidence of ESBL resistance genes (73.0% for bla TEM, 35.1% for bla CTX-M, and 8.1% for bla OXA-1) among E. coli isolated from urine samples in two hospitals (Hôpital National de Niamey and Hôpital National Lamorde) in Niamey [1]. Therefore, it is imperative that the majority of these bacteria are tested for antibiotic resistance, so that strategies can be put in place to halt the continued spread of these pathogens [18]. The current study intended to assess the effectiveness of fosfomycin against ESBL-producing Escherichia coli isolated from patient urine cultures in the General Reference Hospital of Niamey.
2. Materials and Methods
2.1. Study Site, Period, and Data Gathering
To assess the efficacy of fosfomycin against ESBL-producing Escherichia coli isolated from patient urinary cultures in the General Reference Hospital of Niamey (GRHN), Niger, we conducted a prospective sampling of urine. The study was held in the Bacteriology Laboratory of the GRHN from January to December 2021. A total of 3369 urinary samples were collected from hospitalized patients and community patients. Only data from ESBL-producing E. coli isolates were collected on cards in the Bacteriology Laboratory. The urine cultures yielding growths other than extended spectrum beta-lactamases-producing E. coli were eliminated from the study. The request to participate in the study was sent to all the patients and their family members to obtain their positive opinion on the bacteriological analysis of urine.
The macroscopic appearance of the total urine (i.e., non-centrifuged urine) was first assessed. Next, a part of the total urine was introduced into a KOVASLIDE cell to quantify the white blood cells and the red blood cells. Simultaneously, another part of the total urine was centrifuged to qualitatively assess the figurative elements in a pellet placed between a slide and a coverslip under a 40X microscope.
All the urinary samples were inoculated into Cystine–Lactose–Electrolyte-Deficient (CLED) (Himedia, Dindori, Nashik, India) agar and non-selective agar media UriSelect 4 (Bio-Rad, Redmond, WA, USA) following standard bacteriology protocols. The culture media were then placed in a 37 °C incubator for 18–24 h.
2.2. Identification and Antimicrobial Susceptibility Testing
Vitek GN cards were used to identify E. coli isolates and an AST-N372 card was used to determine the E. coli isolates’ sensitivity and resistance to fosfomycin [19]. Each AST card contains a selection of antibiotics in varying concentrations, together with a dehydrated culture medium. In our study, fosfomycin was the focus of attention, with variable concentrations of 8, 16, and 32 µg in different wells of the AST. The results were categorized using the CA-SFM EUCAST 2019 V2 version 9.02 software [20]. ESBL testing was carried out on all C3G-resistant E. coli isolates. A synergy test was performed for the ESBL phenotypic research, which resulted in champagne cork images, using antibiotic discs, amoxicillin-clavulanic acid (20/10 µg), ceftazidime (10 µg), cefepime (30 µg), and cefotaxime (5 µg) on single Mueller–Hinton agar, incubated at 37 °C for 24 h according to the CA-SFM 2019 recommendations [21]. For the E. coli isolates that did not express champagne cork images on the single Mueller–Hinton agar, an additional synergy test was performed by adding 250 mg/L of the cephalosporinase inhibitor cloxacillin to single Mueller–Hinton agar to test for champagne cork images [21].
2.3. Data Analysis and Processing
The data were collected and analyzed with the EPI Info Version 7.2.2.6 software. A p-value of less than 0.05 was considered statistically significant.
3. Results
3.1. Prevalence of ESBL-Producing E. coli Isolates
A total of 3369 urinary samples, i.e., 1651 samples (49%) from male patients and 1718 samples (51%) from female patients, were received in the Bacteriology Laboratory. In these samples, 280 enterobacteria were implicated in urinary tract infections. According to our findings, Escherichia coli was the most common Enterobacterales associated with urinary tract infections. Indeed, out of the 280 enterobacteria, 209 were E. coli isolates, of which 104 were ESBL-producing E. coli (Figure 1), with a frequency of 37.14%, against 105 non-ESBL-producing E. coli isolates, i.e., 37.50%. The other enterobacteria isolates represented were 71, with a frequency of 25.36%.
Figure 1.
Synergy confirmation test for ESBL-producing Escherichia coli. Legend: AMC = amoxicillin-clavulanic acid, CTX = cefotaxime, CAZ = ceftazidime, and CRO = ceftriaxone.
The patients’ average age was 54 ± 17 years. The age range most affected by ESBL-producing E. coli and urinary tract infections was 46–65 years, with frequencies of 58.65% and 48.19%, respectively, followed by the age group over 66 years, with frequencies of 21.15% and 26.51% (Table 1). This suggested that the age range that is most affected by urinary tract infections is also the age range which shows more ESBL-producing E. coli.
Table 1.
Distribution of ESBL-producing Escherichia coli according to socio-demographic aspects and patient status.
Considering the gender distribution, the ESBL-producing E. coli isolates were found more in the female patients, with a frequency of 51.90%, than in the male patients, with a frequency of 48.10%, i.e., a sex ratio of 1.08 (Table 1).
It was also shown that urinary tract infections due to ESBL-producing E. coli isolates were more frequent (75.96%) in the community outpatients compared to the hospitalized inpatients (24.04%) (Table 1).
3.2. Susceptibility of ESBL-Producing E. coli to Fosfomycin
All the isolates were tested for susceptibility to twelve antibiotics belonging to seven classes: amoxicillin-clavulanic acid, temocillin, cefoxitin, ertapenem, imipenem, nalidixic acid, ofloxacin, amikacin, gentamicin, trimethoprim-sulfamethoxazole, fosfomycin, and nitrofurantoin. The ESBL-producing E. coli showed a 99.03% sensibility to fosfomycin compared to a 0.97% resistance. There was no statistically significant difference between the sexes for fosfomycin sensitivity (p = 1.000).
3.3. Antibiotic Resistance Profile of ESBL-Producing Escherichia coli
As far as the antibiotics-resistance profile is concerned, the ESBL-producing E. coli isolates revealed a high degree of E. coli resistance to various antibiotics. Indeed, in contrast with fosfomycin, as shown above, the ESBL-producing E. coli isolates showed high rates of resistance to cotrimoxazole (99.03%), fluoroquinolones (99.03%), and amoxicillin-clavulanic acid (85.58%). However, a low rate of resistance was observed towards cefoxitin (32.69%), amikacin (36.54%), temocillin (46.15%), and gentamicin (55.77%). Antibiotics such as ofloxacin (from the fluoroquinolones group) showed only a 0.97% sensitivity, while the sensitivity patterns of other oral antibiotics were 14.42% for amoxicillin-clavulanate and 0.97% for sulfamethoxazole-trimethoprim.
Interestingly, our findings showed very low resistance rates towards fosfomycin (0.97%), carbapenems (2.88%), and nitrofurantoin (10.58%) (Figure 2).
Figure 2.
Resistance to individual antimicrobial agents among ESBL-producing E. coli.
4. Discussion
The present study showed the resistance to probabilistic antibiotics used to treat urinary infections due to Escherichia coli isolates. Our findings showed a high resistance to the sulfamethoxazole-trimethoprim combination (anti-folates family), the amoxicillin-clavulanic acid combination, and fluoroquinolones (nalidixic acid, ofloxacin). These results are also consistent with those reported by other researchers in different parts of the world [22,23], meaning that many antibiotics once used to treat urinary tract infections are now ineffective because of the development of antimicrobial resistance. Nonetheless, this increase in resistance to traditional antibiotic molecules will lead clinicians to a few new antibiotics, some of which have been recently approved, mostly for intravenous use, like meropenem/vaborbactam, imipenem/cilastatin-relebactam, sulopenem, ceftazidime-avibactam, ceftolozane-tazobactam, and aminoglycosides including plazomicin, cefideroc, sitafloxacin, and finafloxacin [24].
The mean age of the patients with urinary tract infections caused by ESBL-producing Escherichia coli isolates was 54 ± 17 years. This result was similar to those reported in 2021 by different authors in studies conducted in India and Morocco [25,26]. The age group of 46–65 years was the most affected by these ESBL-producing Escherichia coli isolates, and this corroborated what had been found by Jia et al. in China during a clinical study [27]. Our results differ slightly from a greater prevalence reported in the age groups of 61–70 (23.9%) and 71–80 (20.7%) years, in Pakistan [2]. However, the patients in both their study and ours are at an increased risk of developing chronic UTI, since they are elderly patients with low immunity and are generally diabetics, kidney patients, or suffering from other pathologies. Therefore, they must be managed with a better antimicrobial agent with fewer side effects.
When analyzing UTI prevalence according to gender, our results showed that 49% of the patients were male and 51% were female. Reasons such as female anatomy, particularly with regard to the urethra, i.e., the tube which carries urine from the bladder out of the body, may justify this difference. Indeed, the urethra is much shorter in length in women than it is in men, and pathogenic bacteria could easily enter the urinary tract through the urethra.
Our results show that as many ESBL-producing Escherichia coli isolates are involved in urinary tract infections as non-ESBL-producing Escherichia coli. Additionally, the female sex was more favorable to ESBL-producing E. coli, with a frequency of 51.90% against the 48.10% observed for the male sex. In accordance with this finding, the E. coli-produced enzymes extended spectrum beta-lactamases (ESBLs) have been recognized as significant pathogens causing UTI. This pathogenicity is related to the fact that ESBLs are enzymes able to hydrolyze all penicillins, cephalosporins, and monobactams [28]. ESBLs are also responsible for the cross-resistance to co-trimoxazole, fluoroquinolones, and amino glycosides [29]. For all these reasons, ESBLs-producing bacteria commonly pose serious problems in UTI management. Notably, antibiotics such as ofloxacin (fluoroquinolones group) showed only a 0.97% sensitivity, meaning that their use in treating urinary tract infections has decreased. The sensitivity patterns of other oral antibiotics were 14.42% for amoxicillin-clavulanate and 0.97% for sulfamethoxazole-trimethoprim. Indeed, this also explains the response failure of those antibiotics during treatment on an empirical basis. Similar susceptibility patterns were found in a study conducted in Pakistan [2].
The ESBL-producing Escherichia coli isolated in our study presented low rates of resistance to fosfomycin (0.97%). This result is slightly higher than the zero resistance rate reported by other researchers in different parts of the world, such as Sri Lanka in 2019 [30], Morocco in 2021 [26], and India in 2022 [31]. However, other long-term, single-center and multi-center studies reported a 3% fosfomycin resistance rate in 2019 [32] and a 4.6% resistance rate in 2021, respectively [27]. Fosfomycin may be the treatment of choice for urinary tract infections caused by ESBL-producing E. coli isolates in patients. Indeed, fosfomycin has shown a good effectiveness in the laboratory compared to the other first-line antibiotics used [2]. Moreover, fosfomycin comes in the form of a single-dose oral tablet, is easily absorbed in the stomach before food intake, and is eliminated via urine [23]. Fosfomycin has no harmful effects on the body and its microbiota, so several clinical studies have demonstrated an excellent effectiveness of this antibiotic in the treatment of urinary infections compared to the use of other first-line antibiotics. [33,34,35]. It is interesting to note that this antibiotic was introduced into the list of antibiotics to be used as first-line treatments of urinary infections in European countries [36]. In addition, fosfomycin is part of the latest list of first-line antibiotics in the probabilistic treatment of urinary tract infections recommended by the European Association of Urology [37,38,39]. For example, in France, fosfomycin is indicated as a single oral dose for the first-line treatment of cystitis [40]. The data from our study on the effectiveness of fosfomycin against ESBL-producing E. coli confirm the conclusions of previous studies reported by researchers [23,41,42]. Interestingly, our results showed that up to 99.03% of the ESBL-producing E. coli isolates tested for susceptibility were susceptible to fosfomycin, demonstrating an increased efficacy of fosfomycin against isolates of multidrug-resistant Escherichia coli. In line with this, a mini-review of existing data showed that fosfomycin had a high efficacy against Enterobacterales in general, including those expressing enzymes for protection [43]. Despite decades of use, up to the present day, fosfomycin is resistant to the pathogenicity of ESBL-producing E. coli isolates, and this may explain the low resistance rates observed in several studies [44]. Other reasons also explaining the low rate of resistance to fosfomycin in ESBL-producing Escherichia coli isolates may include, certainly, the rapid contact time of the antibiotic with the isolates and its high elimination via urine, in its active form [45].
5. Conclusions
In the present study, fosfomycin showed a high rate of resistance against ESBL-producing Escherichia coli isolates. Our findings suggest that fosfomycin remains the best viable option for the treatment of urinary infections caused by ESBL-producing Escherichia coli isolates. Indeed, fosmocycin is absorbed rapidly in the stomach and presents no negative effects on the microbiota. In addition, it is eliminated in high concentration in urine, in its active form.
Author Contributions
Conceptualization, A.H.M. and R.D.; methodology, A.H.M.; software, A.H.M. and R.D.; validation, R.D., A.I., E.A.O. and N.B.; formal analysis, A.H.M. and R.D.; investigation, A.H.M.; data curation, A.H.M. and R.D.; writing—original draft preparation, A.H.M.; writing—review and editing, R.D., A.M.F., A.B.K., H.C., F.F.B., C.S. and L.B.; and supervision, A.I., E.A.O. and N.B. All authors have read and agreed to the published version of the manuscript.
Funding
This research received no external funding.
Institutional Review Board Statement
The study was conducted according to the guidelines of the Declaration of Helsinki and approved by the Institutional Review Board (or Ethics Committee) of the General Reference Hospital (Reference Code: 000744/DG/HGR/DA/S/SER, date: 16 September 2022).
Informed Consent Statement
Informed consent was obtained from all the subjects involved in the study.
Data Availability Statement
The data presented in this study are available on request from the corresponding authors.
Acknowledgments
The authors thank the authorities of the General Reference Hospital of Niamey and the biology technicians for their assistance with the reagents and their technical support. We also thank the University Joseph KI ZERBO of Ouagadougou for its support and technical advice.
Conflicts of Interest
The authors declare no conflict of interest.
References
- Fody, A.M.; Bagré, T.S.; Traoré, A.; Yacouba, A.; Dembelé, R.; Boubou, L.; Inoussa, A.; Sidikou, R.; Traoré, A.S.; Gassama-Sow, A.; et al. Molecular characterization of extended spectrum beta-lactamase among clinical multidrug resistant Escherichia coli in two hospitals of Niamey, Niger. Afr. J. Clin. Exp. Microbiol. 2018, 19, 1–8. [Google Scholar] [CrossRef]
- Gohar, H.; Afridi, F.I.; Fatima, M.; Fatima, A.; Afzal, N.; Fasih, F. Effectiveness of Fosfomycin against Extended Spectrum Beta-Lactamase Producing Escherichia coli in Urinary Cultures. Pak. J. Med. Dent. 2021, 10, 44–50. [Google Scholar]
- Wilson, D.T.; May, D.B. Potential Role of Fosfomycin in the Treatment of Community-Acquired Lower Urinary Tract Infections Caused by Extended-Spectrum β-Lactamase-Producing Escherichia coli. Am. J. Ther. 2013, 20, 685–690. [Google Scholar] [CrossRef]
- Liu, H.Y.; Lin, H.C.; Lin, Y.C.; Yu, S.H.; Wu, W.H.; Lee, Y.J. Antimicrobial susceptibilities of urinary extended-spectrum beta-lactamase-producing Escherichia coli and Klebsiella pneumoniae to fosfomycin and nitrofurantoin in a teaching hospital in Taiwan. J. Microbiol. Immunol. Infect. 2011, 44, 364–368. [Google Scholar] [CrossRef]
- Djim-Adjim-Ngana, K.; Oumar, L.A.; Mbiakop, B.W.; Njifon, H.L.M.; Crucitti, T.; Nchiwan, E.N.; Yanou, N.N.; Deweerdt, L. Prevalence of extended-spectrum beta-lactamase-producing enterobacterial urinary infections and associated risk factors in small children of Garoua, Northern Cameroon. Pan Afr. Med. J. 2020, 36, 157. [Google Scholar] [CrossRef]
- de Cueto, M.; Aliaga, L.; Alós, J.I.; Canut, A.; Los-Arcos, I.; Martínez, J.A.; Mensa, J.; Pintado, V.; Rodriguez-Pardo, D.; Yuste, J.R. Executive summary of the diagnosis and treatment of urinary tract infection: Guidelines of the Spanish Society of Clinical Microbiology and Infectious Diseases (SEIMC). Enfermedades Infecc. Microbiol. Clin. 2017, 35, 314–320. [Google Scholar] [CrossRef]
- Klein, R.D.; Hultgren, S.J. Urinary tract infections: Microbial pathogenesis, host-pathogen interactions and new treatment strategies. Nat. Rev. Microbiol. 2020, 18, 211–226. [Google Scholar] [CrossRef]
- Rodríguez-Baño, J.; Gutiérrez-Gutiérrez, B.; Machuca, I.; Pascual, A. Treatment of Infections Caused by Extended-Spectrum-Beta-Lactamase-, AmpC-, and Carbapenemase-Producing Enterobacteriaceae. Clin. Microbiol. Rev. 2018, 31, e00079-17. [Google Scholar] [CrossRef]
- Rodriguez-Avial, C.; Rodriguez-Avial, I.; Hernandez, E.; Picazo, J.J. Increasing prevalence of fosfomycin resistance in extended-spectrum-beta-lactamase-producing Escherichia coli urinary isolates (2005–2009–2011). Rev. Espanola Quimioter. 2013, 26, 43–46. [Google Scholar]
- Sagna, T.; Somda, W.D.N.; Koné, A.C.; Sagna, Y.; Tialla, D. Antibiotic Susceptibility of Escherichia coli and Klebsiella pneumoniae Strains, Urinary Tract Infections Cases in Bobo-Dioulasso, Burkina Faso. EC Microbiol. 2019, 15, 172–178. [Google Scholar]
- Falagas, M.E.; Vouloumanou, E.K.; Samonis, G.; Vardakas, K.Z. Fosfomycin. Clin. Microbiol. Rev. 2016, 29, 321–347. [Google Scholar] [CrossRef] [PubMed]
- Dinh, A.; Salomon, J.; Bru, J.P.; Bernard, L. Fosfomycin: Efficacy against infections caused by multidrug-resistant bacteria. Scand. J. Infect. Dis. 2012, 44, 182–189. [Google Scholar] [CrossRef] [PubMed]
- Díez-Aguilar, M.; Cantón, R. New microbiological aspects of fosfomycin. Rev. Española Quimioter. 2019, 32, 8. [Google Scholar]
- Keating, G.M. Fosfomycin trometamol: A review of its use as a single-dose oral treatment for patients with acute lower urinary tract infections and pregnant women with asymptomatic bacteriuria. Drugs 2013, 73, 1951–1966. [Google Scholar] [CrossRef] [PubMed]
- Kahan, F.M.; Kahan, J.S.; Cassidy, P.J.; Kropp, H. The mechanism of action of fosfomycin (phosphonomycin). Ann. N. Y. Acad. Sci. 1974, 235, 364–386. [Google Scholar] [CrossRef] [PubMed]
- Matthews, P.C.; Barrett, L.K.; Warren, S.; Stoesser, N.; Snelling, M.; Scarborough, M.; Jones, N. Oral fosfomycin for treatment of urinary tract infection: A retrospective cohort study. BMC Infect. Dis. 2016, 16, 556. [Google Scholar] [CrossRef] [PubMed]
- Pullukcu, H.; Tasbakan, M.; Sipahi, O.R.; Yamazhan, T.; Aydemir, S.; Ulusoy, S. Fosfomycin in the treatment of extended spectrum beta-lactamase-producing Escherichia coli-related lower urinary tract infections. Int. J. Antimicrob. Agents 2007, 29, 62–65. [Google Scholar] [CrossRef]
- Margulieux, K.R.; Srijan, A.; Ruekit, S.; Nobthai, P.; Poramathikul, K.; Pandey, P.; Serichantalergs, O.; Shrestha, S.K.; Bodhidatta, L.; Swierczewski, B.E. Extended-spectrum β-lactamase prevalence and virulence factor characterization of enterotoxigenic Escherichia coli responsible for acute diarrhea in Nepal from 2001 to 2016. Antimicrob. Resist. Infect. Control. 2018, 7, 87. [Google Scholar] [CrossRef]
- Mohamed, A.H.; Dembélé, R.; Salaou, C.; Kagambèga, A.B.; Coulibaly, H.; Bado, F.F.; Fody, A.M.; Boubou, L.; Ibrahim, I.; Omar, E.A.; et al. Antibiotic Resistance in the Uropathogenic Enterobacteria Isolated from Patients Attending General Reference Hospital (GRH) of Niamey, Niger. Open J. Med. Microbiol. 2023, 13, 78–90. [Google Scholar] [CrossRef]
- Angaali, N.; Vemu, L.; Padmasri, C.; Mamidi, N.; Teja, V.D. Direct identification and susceptibility testing of Gram-negative bacilli from turbid urine samples using VITEK2. J. Lab. Physicians 2018, 10, 299–303. [Google Scholar] [CrossRef]
- CA-SFM/EUCAST 2019. Available online: https://www.bing.com/search?q=CA-SFM+%2F+EUCAST+2019&cvid=876c1b1bccb044a2adb894132c95eac7&aqs=edge..69i57j69i60.4058j0j1&pglt=43&FORM=ANNTA1&PC=U531 (accessed on 30 August 2023).
- Anand, M.; Sahu, C.; Negi, A.; Singh, A. In vitro assessment of fosfomycin: A beacon of hope in drug resistant organisms causing urinary tract infections. J. Adv. Med. Med. Res. 2019, 30, 1–9. [Google Scholar] [CrossRef]
- Hareendranath, G.; Mukundan, A.; Kunjappan, S.P. Fosfomycin Susceptibility in Multidrug Resistant Urinary Escherichia coli Isolates. J. Evol. Med. Dent. Sci. 2021, 10, 414–419. [Google Scholar] [CrossRef]
- Bader, M.S.; Loeb, M.; Leto, D.; Brooks, A.A. Treatment of urinary tract infections in the era of antimicrobial resistance and new antimicrobial agents. Postgrad. Med. 2020, 132, 234–250. [Google Scholar] [CrossRef] [PubMed]
- Kumar, N.; Chatterjee, K.; Deka, S.; Shankar, R.; Kalita, D. Increased isolation of extended-spectrum beta-lactamase-producing Escherichia coli from community-onset urinary tract infection cases in Uttarakhand, India. Cureus 2021, 13, e13837. [Google Scholar] [CrossRef] [PubMed]
- Kettani Halabi, M.; Lahlou, F.A.; Diawara, I.; El Adouzi, Y.; Marnaoui, R.; Benmessaoud, R.; Smyej, I. Antibiotic resistance pattern of extended spectrum beta lactamase producing Escherichia coli isolated from patients with urinary tract infection in Morocco. Front. Cell. Infect. Microbiol. 2021, 11, 720701. [Google Scholar] [CrossRef] [PubMed]
- Jia, P.; Zhu, Y.; Li, X.; Kudinha, T.; Yang, Y.; Zhang, G.; Zhang, J.; Xu, Y.; Yang, Q. High prevalence of extended-spectrum beta-lactamases in Escherichia coli strains collected from strictly defined community-acquired urinary tract infections in adults in China: A multicenter prospective clinical microbiological and molecular study. Front. Microbiol. 2021, 12, 663033. [Google Scholar] [CrossRef] [PubMed]
- Padmini, N.; Ajilda, A.A.K.; Sivakumar, N.; Selvakumar, G. Extended spectrum β-lactamase producing Escherichia coli and Klebsiella pneumoniae: Critical tools for antibiotic resistance pattern. J. Basic Microbiol. 2017, 57, 460–470. [Google Scholar] [CrossRef] [PubMed]
- Abayneh, M.; Tesfaw, G.; Abdissa, A. Isolation of extended-spectrum β-lactamase-(ESBL-) producing Escherichia coli and Klebsiella pneumoniae from patients with community-onset urinary tract infections in Jimma University Specialized Hospital, Southwest Ethiopia. Can. J. Infect. Dis. Med. Microbiol. 2018, 2018, 4846159. [Google Scholar] [CrossRef]
- Priyadharshana, U.; Piyasiri, L.B.; Wijesinghe, C. Prevalence, antibiotic sensitivity pattern and genetic analysis of extended spectrum beta lactamase producing Escherichia coli and Klebsiella spp. among patients with community acquired urinary tract infection in Galle district, Sri Lanka. Ceylon Med. J. 2019, 64, 140–145. [Google Scholar] [CrossRef]
- Mahajan, K.D.; Joshi, R. Evaluation of clinical Spectrum, antibiotic Sensitivity, and clinical Outcome in pediatric Age Group (0–18 Years) with Extended-spectrum Beta-lactamase-producing Escherichia coli-associated Urinary Tract Infection in Tertiary Care Hospital in India. Pediatr. Infect. Dis. 2022, 4, 133–137. [Google Scholar] [CrossRef]
- Aris, P.; Boroumand, M.A.; Rahbar, M.; Douraghi, M. The activity of fosfomycin against extended-spectrum beta-lactamase-producing isolates of Enterobacteriaceae recovered from urinary tract infections: A single-center study over a period of 12 years. Microb. Drug Resist. 2018, 24, 607–612. [Google Scholar] [CrossRef]
- Dijkmans, A.C.; Ortiz Zacarías, N.V.; Burggraaf, J.; Mouton, J.W.; Wilms, E.B.; Van Nieuwkoop, C.; Touw, D.J.; Stevens, J.; Kamerling, I.M. Fosfomycin: Pharmacological, clinical and future perspectives. Antibiotics 2017, 6, 24. [Google Scholar] [CrossRef] [PubMed]
- Falagas, M.E.; Kastoris, A.C.; Kapaskelis, A.M.; Karageorgopoulos, D.E. Fosfomycin for the treatment of multidrug-resistant, including extended-spectrum β-lactamase producing, Enterobacteriaceae infections: A systematic review. Lancet Infect. Dis. 2010, 10, 43–50. [Google Scholar] [CrossRef] [PubMed]
- Neuner, E.A.; Sekeres, J.; Hall, G.S.; van Duin, D. Experience with fosfomycin for treatment of urinary tract infections due to multidrug-resistant organisms. Antimicrob. Agents Chemother. 2012, 56, 5744–5748. [Google Scholar] [CrossRef]
- Cai, T.; Palagin, I.; Brunelli, R.; Cipelli, R.; Pellini, E.; Truzzi, J.C.; Van Bruwaene, S. Office-based approach to urinary tract infections in 50 000 patients: Results from the REWIND study. Int. J. Antimicrob. Agents 2020, 56, 105966. [Google Scholar] [CrossRef]
- Gupta, K.; Hooton, T.M.; Naber, K.G.; Wullt, B.; Colgan, R.; Miller, L.G.; Moran, G.J.; Nicolle, L.E.; Raz, R.; Schaeffer, A.J. International clinical practice guidelines for the treatment of acute uncomplicated cystitis and pyelonephritis in women: A 2010 update by the Infectious Diseases Society of America and the European Society for Microbiology and Infectious Diseases. Clin. Infect. Dis. 2011, 52, e103–e120. [Google Scholar] [CrossRef] [PubMed]
- Bonkat, G.; Bartoletti, R.; Bruyere, F.; Cai, T.; Geerlings, S.; Köves, B.; Schubert, S.; Wagenlehner, F.; Mezei, T.; Pilatz, A. EAU guidelines on urological infections. Eur. Assoc. Urol. 2017, 18, 22–26. [Google Scholar]
- Bonkat, G.; Bartoletti, R.; Bruyere, F.; Cai, T.; Geerlings, S.; Köves, B.; Schubert, S.; Wagenlehner, F. EAU Guideline of Urological Infections. Eur. Assoc. Urol. 2022, 78. Available online: https://d56bochluxqnz.cloudfront.net/documents/full-guideline/EAU-Guidelines-on-Urological-Infections-2022.pdf (accessed on 30 August 2023).
- Bouiller, K.; Zayet, S.; Lalloz, P.E.; Potron, A.; Gendrin, V.; Chirouze, C.; Klopfenstein, T. Efficacy and Safety of Oral Fosfomycin-Trometamol in Male Urinary Tract Infections with Multidrug-Resistant Enterobacterales. Antibiotics 2022, 11, 198. [Google Scholar] [CrossRef]
- Sardar, A.; Basireddy, S.R.; Navaz, A.; Singh, M.; Kabra, V. Comparative evaluation of fosfomycin activity with other antimicrobial agents against E. coli isolates from urinary tract infections. J. Clin. Diagn. Res. JCDR 2017, 11, DC26. [Google Scholar]
- Tutone, M.; Johansen, T.E.B.; Cai, T.; Mushtaq, S.; Livermore, D.M. Susceptibility and Resistance to fosfomycin and other antimicrobial agents among pathogens causing lower urinary tract infections: Findings of the SURF study. Int. J. Antimicrob. Agents 2022, 59, 106574. [Google Scholar] [CrossRef]
- Kot, B. Antibiotic resistance among uropathogenic. Pol. J. Microbiol. 2019, 68, 403–415. [Google Scholar] [CrossRef] [PubMed]
- Hashemian, S.M.R.; Farhadi, Z.; Farhadi, T. Fosfomycin: The characteristics, activity, and use in critical care. Ther. Clin. Risk Manag. 2019, 15, 525–530. [Google Scholar] [CrossRef] [PubMed]
- Zhanel, G.G.; Walkty, A.J.; Karlowsky, J.A. Fosfomycin: A first-line oral therapy for acute uncomplicated cystitis. Can. J. Infect. Dis. Med. Microbiol. 2016, 2016, 2082693. [Google Scholar] [CrossRef] [PubMed]
Disclaimer/Publisher’s Note: The statements, opinions and data contained in all publications are solely those of the individual author(s) and contributor(s) and not of MDPI and/or the editor(s). MDPI and/or the editor(s) disclaim responsibility for any injury to people or property resulting from any ideas, methods, instructions or products referred to in the content. |
© 2023 by the authors. Licensee MDPI, Basel, Switzerland. This article is an open access article distributed under the terms and conditions of the Creative Commons Attribution (CC BY) license (https://creativecommons.org/licenses/by/4.0/).